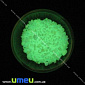
Фосфоресцентна крихта зеленого світіння (DIF-006791)

Декоративный наполнитель
Як вказати упаковку?
×


Проведіть по товару, щоб відкрити вибір упаковки
-
Бульонки бірюзові (DIF-008691)
 Не в наявності
Не в наявності- 1 уп (1 г) ЗАКІНЧИВСЯ
- Артикул DIF-008691
- Колір Бірюзовий
Ціна за упаковку 1 грам. -
-
Бульонки блакитні (DIF-006763)
 Не в наявності
Не в наявності- 1 уп (1 г) ЗАКІНЧИВСЯ
- Артикул DIF-006763
- Колір Блакитний
Ціна за упаковку 1 грам. -
-
Бульонки зелені (DIF-006760)
 Не в наявності
Не в наявності- 1 уп (1 г) ЗАКІНЧИВСЯ
- Артикул DIF-006760
- Колір Зелений
Ціна за упаковку 1 грам. -
-
Бульонки золотисті (DIF-006762)
 Не в наявності
Не в наявності- 1 уп (1 г) ЗАКІНЧИВСЯ
- Артикул DIF-006762
- Колір Золотистий
Ціна за упаковку 1 грам. -
-
Бульонки смарагдові (DIF-008690)
 Не в наявності
Не в наявності- 1 уп (1 г) ЗАКІНЧИВСЯ
- Артикул DIF-008690
- Колір Смарагдовий
Ціна за упаковку 1 грам. -
-
Бульонки червоні (DIF-006765)
 Не в наявності
Не в наявності- 1 уп (1 г) ЗАКІНЧИВСЯ
- Артикул DIF-006765
- Колір Червоний
Ціна за упаковку 1 грам. -
-
Бульонки малинові (DIF-006766)
 Не в наявності
Не в наявності- 1 уп (1 г) ЗАКІНЧИВСЯ
- Артикул DIF-006766
- Колір Малиновий
Ціна за упаковку 1 грам. -
-
Бульонки рожеві (DIF-006767)
 Не в наявності
Не в наявності- 1 уп (1 г) ЗАКІНЧИВСЯ
- Артикул DIF-006767
- Колір Рожевий
Ціна за упаковку 1 грам. -
-
Бульонки рожеві (DIF-008687)
 Не в наявності
Не в наявності- 1 уп (1 г) ЗАКІНЧИВСЯ
- Артикул DIF-008687
- Колір Рожевий
Ціна за упаковку 1 грам. -
-
Бульонки світло-золотисті (DIF-008689)
 Не в наявності
Не в наявності- 1 уп (1 г) ЗАКІНЧИВСЯ
- Артикул DIF-008689
- Колір Світло-золотистий
Ціна за упаковку 1 грам. -
-
Бульонки сріблясті (DIF-008688)
 Не в наявності
Не в наявності- 1 уп (1 г) ЗАКІНЧИВСЯ
- Артикул DIF-008688
- Колір Сріблястий
Ціна за упаковку 1 грам. -
-
Бульонки сині (DIF-006761)
 Не в наявності
Не в наявності- 1 уп (1 г) ЗАКІНЧИВСЯ
- Артикул DIF-006761
- Колір Синій
Ціна за упаковку 1 грам. -
-
Бульонки сині (DIF-006764)
 Не в наявності
Не в наявності- 1 уп (1 г) ЗАКІНЧИВСЯ
- Артикул DIF-006764
- Колір Синій
Ціна за упаковку 1 грам. -
-
Бульонки фіолетові (DIF-006759)
 Не в наявності
Не в наявності- 1 уп (1 г) ЗАКІНЧИВСЯ
- Артикул DIF-006759
- Колір Фіолетовий
Ціна за упаковку 1 грам. -
-
Декоративний дерев'яний зріз (DIF-006751)
 Не в наявності
Не в наявності- 1 шт ЗАКІНЧИВСЯ
- Артикул DIF-006751
- Матеріал Дерево
Так як це природний матеріал, розмір варіюється від 12 мм до 20 мм. -
-
Тримач для плоскої основи, 4х3,5 мм, Антична бронза (DIF-006735)
 Не в наявності
Не в наявності- 1 шт ЗАКІНЧИВСЯ
- Артикул DIF-006735
- Колір Антична бронза
- Матеріал Метал
- Розмір 4х3,5 мм
- Колір металу ан. бронза
Тримач з петелькою сідає на клей. -
-
Тримач для плоскої основи, 4х3,5 мм, Світле срібло (DIF-006734)
 Не в наявності
Не в наявності- 1 шт ЗАКІНЧИВСЯ
- Артикул DIF-006734
- Колір Світле срібло
- Матеріал Метал
- Розмір 4х3,5 мм
- Колір металу св. срібло
Тримач з петелькою сідає на клей. -
-
Тримач для скляної колби, 6х6 мм, Антична бронза (DIF-006737)
 Не в наявності
Не в наявності- 1 шт ЗАКІНЧИВСЯ
- Артикул DIF-006737
- Колір Антична бронза
- Матеріал Метал
- Розмір 6х6 мм
- Колір металу ан. бронза
Тримач з петелькою сідає на клей. -
-
Тримач для скляної колби, 6х6 мм, Світле срібло (DIF-006736)
 Не в наявності
Не в наявності- 1 шт ЗАКІНЧИВСЯ
- Артикул DIF-006736
- Колір Світле срібло
- Матеріал Метал
- Розмір 6х6 мм
- Колір металу св. срібло
Тримач з петелькою сідає на клей. -
-
Морський набір для декору (DIF-006752)
 Не в наявності
Не в наявності- 1 шт ЗАКІНЧИВСЯ
- Артикул DIF-006752
-
-
Пластикова фігурка Гриб, 17х12 мм (DIF-006740)
 Не в наявності
Не в наявності- 1 шт ЗАКІНЧИВСЯ
- Артикул DIF-006740
- Матеріал Пластик
- Розмір 17х12 мм
-
-
Мушля декоративна морська (DIF-010136)
 Не в наявності
Не в наявності- 1 уп (50 г) ЗАКІНЧИВСЯ
- Артикул DIF-010136
Ціна за 50 грам.
Приблизна кількість 18-26 шт.
Розмір черепашки 15-40 мм. -
Мушля декоративна морська (DIF-038749)
 Не в наявності
Не в наявності- 1 уп (50 г) ЗАКІНЧИВСЯ
- Артикул DIF-038749
Ціна за 50 грам.
Приблизна кількість 20-30 шт.
Розмір черепашки 15-40 мм. -
Мушля декоративна спіральна (DIF-010135)
 Не в наявності
Не в наявності- 1 уп (10 г) ЗАКІНЧИВСЯ
- Артикул DIF-010135
Ціна за 10 грам.
Приблизна кількість 30-35 шт.
Розмір черепашки 10-20 мм. -
-
Фосфоресцентна крихта блакитного світіння (DIF-006790)
 Не в наявності
Не в наявності- 1 уп (1 г) ЗАКІНЧИВСЯ
- Артикул DIF-006790
- Колір Блакитний
Ціна за упаковку 1 грам. -
-
Фосфоресцентна крихта зеленого світіння (DIF-006791)
 Не в наявності
Не в наявності- 1 уп (1 г) ЗАКІНЧИВСЯ
- Артикул DIF-006791
- Колір Зелений
Ціна за упаковку 1 грам. -
-
Фосфоресцентна крихта червоного світіння (DIF-008686)
 Не в наявності
Не в наявності- 1 уп (1 г) ЗАКІНЧИВСЯ
- Артикул DIF-008686
- Колір Червоний
Ціна за упаковку 1 грам. -
-
Фосфоресцентна крихта синього світіння (DIF-008685)
 Не в наявності
Не в наявності- 1 уп (1 г) ЗАКІНЧИВСЯ
- Артикул DIF-008685
- Колір Синій
Ціна за упаковку 1 грам. -
Товари
1 - 28 із 28